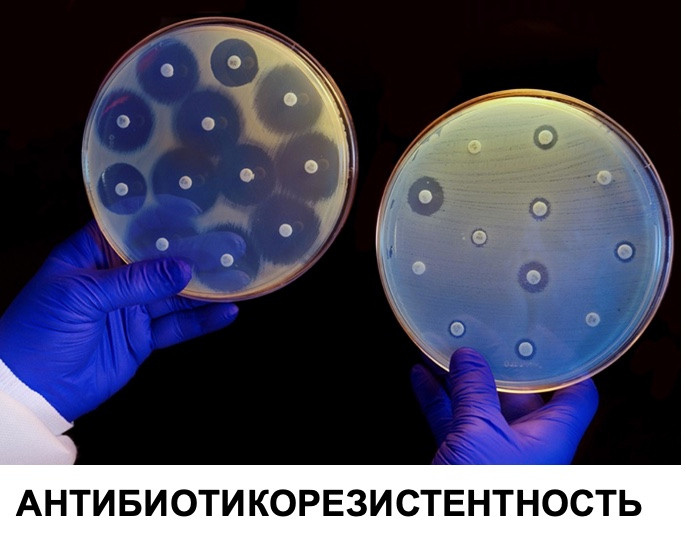
Клеточное мясо. Главная

Проект реализуется в рамках программы «Приоритет-2030»
Культивируемые мясные продукты
Цель
Разработка экономически выгодной технологии производства гибридных культивируемых мясных продуктов
Задачи проекта
Разработка и испытания лабораторного прототипа
Разработка промышленной технологии со стоимостью продукта $10/кг
Создание банка промышленных клеточных линий
Внедрение технологии в производство
Уникальность
Безопасный и экономически выгодный способ производства мясных продуктов
Возможность получения продукта с заданными свойствами
Потенциальный заказчик
Рестораны массового питания
Производители мясных полуфабрикатов

Решение





